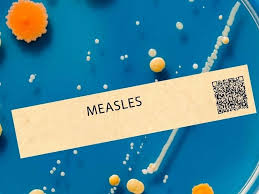

Measles Case Confirmed in Orange County

South Orange County, CA - January 29th, 2026 - Public health officials in Orange County confirmed a case of measles on Wednesday, sparking renewed concerns about potential outbreaks of the highly contagious disease. The Orange County Health Care Agency (OCHCA) is actively investigating the incident and urging residents to be vigilant for symptoms and to take preventative measures, particularly vaccination.
This case marks the first confirmed instance of measles in Orange County in over three years, raising anxieties that waning immunity, coupled with potential declines in vaccination rates, could lead to a wider resurgence of the illness. While a single case doesn't necessarily indicate a full-blown outbreak, experts emphasize the importance of proactive measures to contain it and prevent further spread.
Measles, a viral infection primarily spread through respiratory droplets produced by coughing or sneezing, is notoriously contagious. It's so infectious that if one person has measles, 90% of those who are not immune and are exposed will catch the disease. This high transmission rate underscores the crucial role of community immunity - also known as herd immunity - in protecting vulnerable populations.
"Measles isn't just a childhood illness you 'get over,'" explains Dr. Matthew Zahniser, Medical Director for Communicable Disease at OCHCA. "It can lead to serious complications, including pneumonia, encephalitis (brain swelling), and even death, particularly in young children, pregnant women, and individuals with compromised immune systems. We are taking this case seriously and want the public to understand the potential risks."
Symptoms of measles typically manifest 10-14 days after exposure. These initial symptoms often resemble a common cold, including a high fever (often exceeding 104?F), a persistent cough, a runny nose, and conjunctivitis (red, watery eyes). A characteristic rash then appears, usually starting on the face and spreading to the rest of the body. This rash is composed of small, red spots that may merge together.
The Power of Vaccination The most effective way to protect against measles is through vaccination. The measles, mumps, and rubella (MMR) vaccine is considered safe and highly effective. The Centers for Disease Control and Prevention (CDC) recommends that children receive two doses of the MMR vaccine: the first between 12 and 15 months of age, and the second between 4 and 6 years of age.
Adults who were born in 1957 or later and do not have evidence of immunity (through vaccination or documented history of having had measles) should also be vaccinated. Health officials are also urging individuals planning international travel to ensure they are up-to-date on their MMR vaccinations, as measles remains common in many parts of the world.
Addressing Vaccination Concerns
Recent years have seen a concerning trend of vaccine hesitancy, fueled by misinformation and unfounded fears. While vaccine safety is continuously monitored and rigorously tested, these anxieties persist and contribute to lower vaccination rates, creating pockets of vulnerability within communities. Public health experts are working to address these concerns through education and open communication, emphasizing the overwhelming scientific consensus supporting the safety and efficacy of vaccines.
The OCHCA is urging anyone who believes they may have been exposed to measles, or who are experiencing symptoms, to immediately contact their healthcare provider before visiting a doctor's office or emergency room. This allows healthcare professionals to take appropriate precautions to prevent further spread of the virus.
Further information about measles, including symptoms, prevention, and vaccination resources, can be found on the Orange County Health Care Agency website (https://www.ochealthinfo.com/) and the CDC website (https://www.cdc.gov/measles/index.html). The agency will provide updates as the investigation progresses.
Read the Full Patch Article at:
https://patch.com/california/orange-county/measles-case-reported-south-oc
Like: 👍
on: Tue, Jan 20th
by: Patch

on: Tue, Jan 27th
by: Patch

on: Tue, Jan 20th
by: Patch

on: Tue, Jan 20th
by: Patch

on: Mon, Jan 12th
by: Patch

on: Fri, Dec 05th 2025
by: Patch
Measles Exposure at Brooklyn Supermarket Sparks Rapid Health Response

on: Tue, Jan 20th
by: Patch

on: Wed, Nov 26th 2025
by: Patch
Measles Detected in New York County: 5-Year-Old Child Sparks Urgent Response

on: Tue, Oct 07th 2025
by: WYFF
Health officials confirm additional cases of measles in the Upstate

on: Tue, Oct 07th 2025
by: MLive
Second measles case confirmed by Muskegon County Public Health

on: Fri, Jan 23rd
by: Patch

on: Tue, Dec 30th 2025
by: Patch

















































